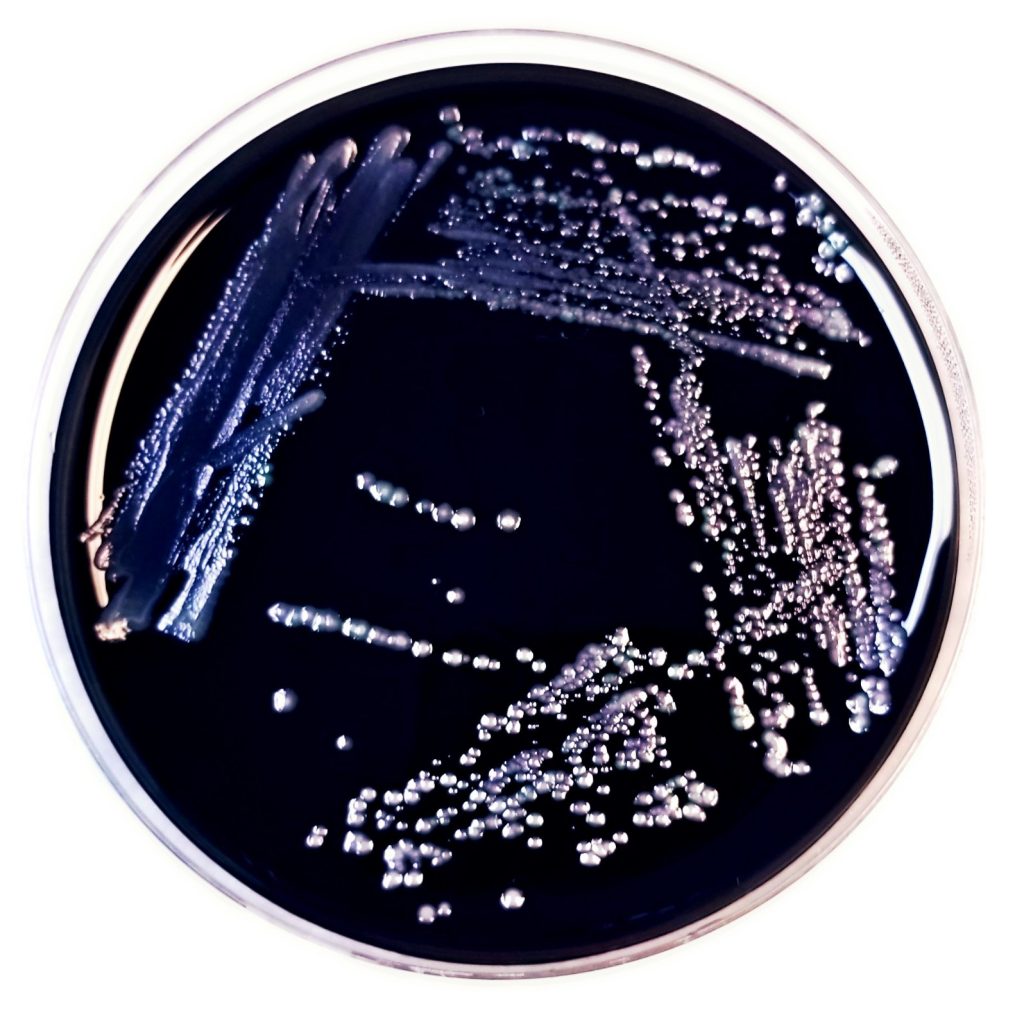
CDC ELITE laboratory expert resource for Legionella testing

About
LegionellaTX is your CDC ELITE laboratory expert resource for Legionella testing. You can order our easy-to-use and affordable DIY Legionella Sample Kits or request a quote for collection services. Our services give you the best options for ordering and scheduling your Legionella testing quickly and efficiently.
Who We Are
We are Legionella testing specialists. Our in-house laboratory, under Hyperion Biotechnology, Inc., is CDC ELITE and EMLAP accredited for Legionella testing. Our experience, and high testing standards under ISO 17025, helps our customers verify the safety of their water systems.
Our Legionella order specialists provide personalized service and are ready to answer any questions you may have. Contact us.
Who We Serve
We serve building owners, facility managers, environmental health departments, infectious disease control managers and anyone involved in the maintenance and safety of a building’s water system.
- Hospitals
- Nursing Homes
- Long-Term Care Facilities
- Stand Alone Emergency Centers
- Senior Living Homes
- Assisted Living Facilities
- Athletic Facilities and Gyms
- Buildings with Cooling Towers
- Facilities with Hot Tubs
- Spas and Salons
- Apartment Buildings
- Residential Homes
- Chemical Treatment Companies
- Environmental Consulting Agencies
- Schools
- Hotels
Facility owners can maintain safety by reducing the risk for Legionella outbreaks with routine water testing.

What We Do

We help you ensure the safety of your building’s water. Whether you follow a water management plan or not, water sampling and laboratory testing is the only way to verify if your system is free of harmful Legionella bacteria.
We test your samples using the reliable culture method. Known as the “gold standard” for Legionella water testing, this method aligns with CDC ELITE protocols. Our laboratory follows CDC ELITE Legionella Procedures and EMLAP culture methods under ISO 11731:2017 for Legionella bacteria.
Facility owners need to reduce the risk of Legionella in order to reduce the risk of an outbreak of Legionnaires’ disease, a serious respiratory illness. If Legionella is in a water system and then aerosolizes through a faucet, shower or other source, vulnerable populations can become ill. Learn more on our FAQ page.
